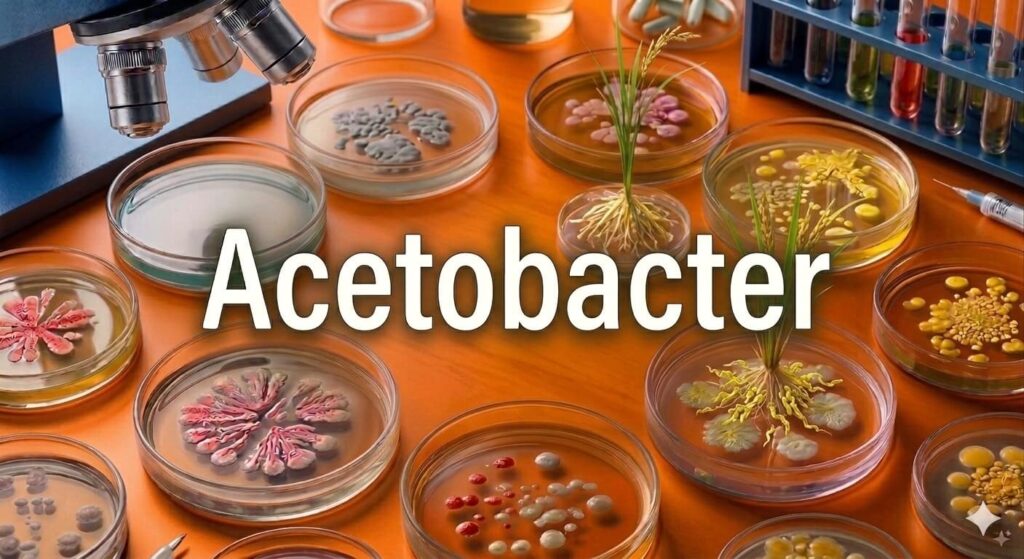
Acetobacter

If you have ever sipped fresh sugarcane juice on a hot day, you have experienced the kind of sweet environment that Acetobacter loves most. While many helpful bacteria work outside in the soil, this one prefers a more comfortable life inside the plant itself. It settles within sugarcane stems, surrounded by natural sugars. But it is not just enjoying the sweetness — it gives something valuable in return. It helps the plant grow by fixing nitrogen and supporting overall health.
What is Acetobacter
The most well-known species is Acetobacter diazotrophicus, now called Gluconacetobacter diazotrophicus. Unlike many other nitrogen-fixing bacteria that live in the soil, this one is endophytic, which means it lives inside plant tissues. It was first discovered in sugarcane, but scientists have also found it in other sweet crops such as sweet potato, pineapple, coffee, and beetroot. Its preference for sugary plants is not a coincidence. It needs high amounts of sugar as an energy source to carry out its activities, especially nitrogen fixation. This makes it different from soil bacteria like Azotobacter or Azospirillum, which depend on organic matter in the soil for energy.
Nitrogen Fixation From Inside the Plant
The main role of Acetobacter is biological nitrogen fixation. Using the enzyme nitrogenase, it converts nitrogen gas from the air into ammonia — a form the plant can use. What makes this process special is where it happens. Since the bacteria live inside the plant, the fixed nitrogen is delivered directly into the plant’s internal system. There is no need for the nitrogen to pass through the soil first. Because of this direct supply, very little nitrogen is lost through leaching or evaporation. This makes the process highly efficient compared to many soil-based nitrogen sources.
A Natural Growth Promoter
Acetobacter does more than provide nitrogen. It also acts as a natural growth promoter inside the plant. It produces plant hormones such as indole acetic acid (IAA), which stimulates root branching and helps the plant absorb more water and nutrients. It also releases gibberellins, which encourage stem elongation and increase plant height, giving sugarcane its tall and vigorous appearance. In addition, Acetobacter produces cytokinins, which delay leaf aging and keep foliage greener for longer, improving photosynthesis.
Nutrients, Vitamins and Disease Protection
Beyond hormones, it secretes organic acids that improve nutrient availability, making phosphorus, iron, and other micronutrients easier for the plant to absorb. It also produces vitamins like B-complex and nicotinic acid, which support metabolic activities and energy transfer inside plant cells. Some strains even release antimicrobial substances that suppress harmful fungi and bacteria, helping protect crops from disease.
Visible Benefits in the Field
Together, these benefits explain why fields treated with Acetobacter often show stronger root systems, taller stalks, greener leaves, and higher yields — all with less dependence on chemical fertilizers.
Reducing Dependence on Chemical Nitrogen
One of the most important advantages of Acetobacter is its ability to reduce the need for synthetic nitrogen fertilizers. Studies have shown that sugarcane farmers can lower nitrogen fertilizer use without reducing yield when Acetobacter is properly applied. Since sugarcane normally requires large amounts of nitrogen, this offers both economic and environmental benefits.
How to Apply Acetobacte
Acetobacter is commonly available as a liquid biofertilizer applied during planting
Conclusion
In simple terms, Acetobacter is a quiet helper living inside the plant, turning sweetness into strength and helping farmers grow healthier crops with fewer chemicals. What makes it truly special is not just one thing it does — it is everything it does together. It fixes nitrogen directly inside the plant, produces growth hormones that build stronger roots and taller stems, protects crops from disease, and makes other nutrients more available — all at the same time, all from within.
For sugarcane farmers in particular, Acetobacter offers something that no chemical fertilizer can match — a living partnership that grows with the crop, season after season. Chemical nitrogen feeds the plant once and disappears. Acetobacter stays, works continuously, and improves the plant from the inside out.
As input costs rise and soil health continues to decline under heavy chemical use, the value of a biofertilizer like Acetobacter becomes impossible to ignore. It costs less, causes no environmental harm, and delivers benefits that go far beyond simple nitrogen supply. For farmers looking for a smarter, more sustainable way to grow sugarcane and other sweet crops, Acetobacter is not just an option — it is one of the best decisions they can make for their fields, their yields, and their future.